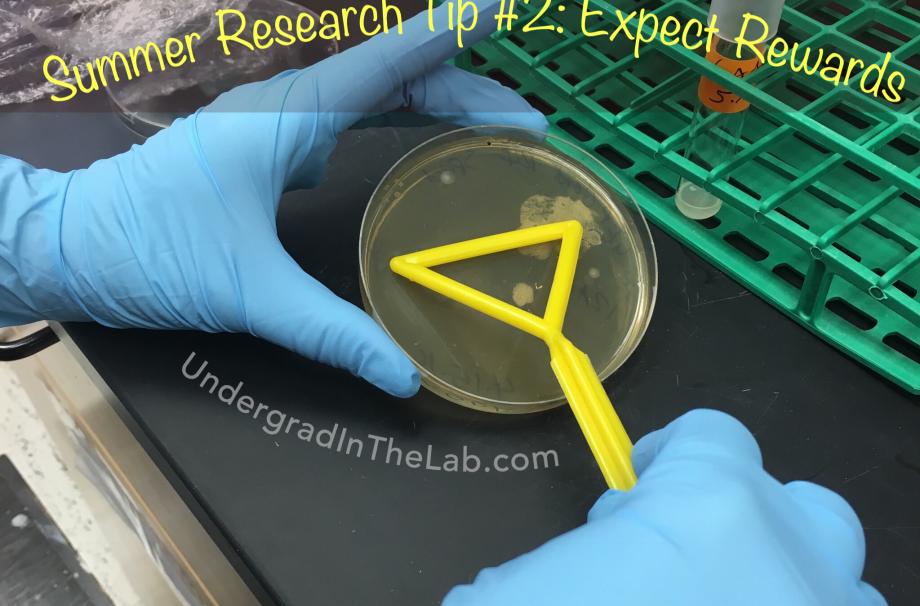
a person spreading bacterial on a petri dish

Tip #2 for Full-Time Summer Researchers: Expect Greater Rewards
Tip #2 for Full-Time Summer Researchers: Expect Greater Rewards
Spending your summer doing research full-time? Expect to gain greater rewards than a regular semester experience.
More time in the lab means more opportunities to take a greater role in planning and conducting experiments, collecting data, and analyzing results.
You might have the option of working on an independent project as the “student PI” with all the responsibilities and rewards that accompany the title.
Additional hours in the lab will also lead to more opportunities to learn, contribute, and become an integral member of the research team.
And when you are given more responsibilities in the lab, it is a definite sign that you’re doing something right.
Want more tips for thriving during your summer research experience? Check out 10 Things to Expect From Your Summer Undergrad Research Experience and On why it’s so important to 5 Survival Tips for Summer Research